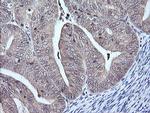
MAP2K3 Antibody in Immunohistochemistry (Paraffin) (IHC (P))

Search
OriGene
MAP2K3 Monoclonal Antibody (OTI6C6), TrueMAB™
{{$productOrderCtrl.translations['antibody.pdp.commerceCard.promotion.promotions']}}
{{$productOrderCtrl.translations['antibody.pdp.commerceCard.promotion.viewpromo']}}
{{$productOrderCtrl.translations['antibody.pdp.commerceCard.promotion.promocode']}}: {{promo.promoCode}} {{promo.promoTitle}} {{promo.promoDescription}}. {{$productOrderCtrl.translations['antibody.pdp.commerceCard.promotion.learnmore']}}
产品信息
TA505644
种属反应
宿主/亚型
分类
类型
克隆号
抗原
偶联物
形式
浓度
纯化类型
保存液
内含物
保存条件
运输条件
靶标信息
MAP2K3 (MEK3) is a dual-specificity protein kinase which acts in cellular signal transduction pathways, and is necessary for the expression of glucose transporter. It phosphorylates and thus activates MAPK14/p38-MAPK. This kinase can be activated by insulin, and is necessary for the expression of glucose transporter. Expression of RAS oncogene is found to result in the accumulation of the active form of this kinase, which thus leads to the constitutive activation of MAPK14, and confers oncogenic transformation of primary cells. The inhibition of this kinase is involved in the pathogenesis of Yersina pseudotuberculosis. Multiple alternatively spliced transcript variants that encode distinct isoforms have been reported for MEK3.
仅用于科研。不用于诊断过程。未经明确授权不得转售。
篇参考文献 (0)
生物信息学
蛋白别名: Dual specificity mitogen-activated protein kinase kinase 3; EC 2.7.12.2; MAP kinase kinase 3; MAPK/ERK kinase 3; MAPKK 3; MEK 3; SAPK kinase 2; Stress-activated protein kinase kinase 2
基因别名: MAP2K3; MAPKK3; MEK3; MKK3; PRKMK3; SAPKK-2; SAPKK2; SKK2
UniProt ID: (Human) P46734
Entrez Gene ID: (Human) 5606